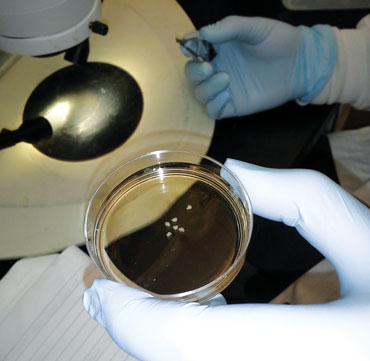

How to build a human brain
Some steps for growing mini versions of human organs are easier than others
BRAIN-MAKING 101 As blobs of two types of brainlike tissue fuse, interneurons (green) migrate from the left clump to the right, linking with neurons (not stained) in the right blob. On both sides, neural support cells called glia appear in purple.
Paşca Lab/Stanford Univ.
In a white lab coat and blue latex gloves, Neda Vishlaghi peers through a light microscope at six milky-white blobs. Each is about the size of a couscous grain, bathed in the pale orange broth of a petri dish. With tweezers in one hand and surgical scissors in the other, she deftly snips one tiny clump in half.
When growing human brains, sometimes you need to do some pruning.
The blobs are 8-week-old bits of brainlike tissue. While they wouldn’t be mistaken for Lilliputian-sized brains, some of their fine-grained features bear a remarkable resemblance to the human cerebral cortex, home to our memories, decision making and other high-level cognitive powers.
Vishlaghi created these “minibrains” at the Eli and Edythe Broad Center of Regenerative Medicine and Stem Cell Research at UCLA, where she’s a research assistant. First she immersed batches of human pluripotent stem cells — which can morph into any cell type in the body — in a special mix of chemicals.
The free-floating cells multiplied and coalesced into itty-bitty balls of neural tissue. Nurtured with meticulously timed doses of growth-supporting ingredients, the cell clumps were eventually transferred to petri dishes of broth laced with Matrigel, a gelatin-like matrix of proteins.
On day 56, the blobs display shadowy clusters of neural “rosettes.” Under a laser scanning microscope, razor-thin slices of those rosettes reveal loose-knit layers of a variety of dividing neural stem cells and the nerve cells, or neurons, they give rise to. The layered structures look similar to the architecture of a human fetal brain at 14 weeks of gestation.

Across the globe, labs such as this one, led by UCLA developmental biologist and neuroscientist Bennett Novitch, are cultivating thousands of these brainy clumps for research. Less than five years ago, a team of biologists in Austria and the United Kingdom and one in Japan wowed the world when they announced they had made rudimentary bits of 3-D human cerebral cortex in a dish. Since then, researchers have been eagerly tinkering with techniques for producing these miniature brain models, like chefs obsessively refining their favorite recipes.
“It’s like making a cake: You have many different ways in which you can do it,” says Novitch, who prefers using the Japanese method with a few tweaks. “There are all sorts of little tricks that people have come up with to overcome some of the common challenges.”
For instance, because the brain blobs lack a built-in blood supply, they must absorb enough oxygen and nutrients from the tissue-culture broth to remain healthy. To help, some labs circulate the broth around the tissue clumps. The UCLA researchers choose instead to grow theirs at higher oxygen levels and chop the blobs at the 35-day mark, when they are as wide as three millimeters, and then about every two weeks after. Sounds radical, but the slicing gives cells on the inside — some of which start dying — exposure to much-needed oxygen and nutrients. Those divided bits then continue growing separately. But cutting can be done only so many times before the expanding rosette structures inside are damaged.
With all the experimenting, researchers have cooked up a lot of innovations, including some nifty progress reported in just the last year. Scientists have concocted tiny versions of several brain regions ranging from the hypothalamus, which regulates body temperature, thirst and hunger, to the movement-controlling basal ganglia. Electrical chatter among neurons, reflecting active brain circuits, has been detected. And research groups have recently begun linking bits of specific regions like Legos. Scientists have even observed some early developmental processes as they happen within the human brain blobs.
Stem cell payoff
The work is part of a broader scientific bonanza that comes from coaxing human stem cells to self-assemble into balls of organlike tissue, known as organoids, that are usually no bigger than a lentil. Although the organoids don’t grow enough to replicate entire human organs, these mini-versions can mimic the 3-D cellular infrastructure of everything from our guts to our lungs. That’s something you can’t get from studies of rodents, which have different biology than humans do.
Mini-organ models promise enormous advantages for understanding basic human biology, teasing apart human disease processes, and offering an accurate testing ground for finding or vetting drug therapies. And by creating personalized organoids from the reprogrammed cells of patients, scientists could study disease in a very individualized way — or maybe even use organoid structures to replace certain damaged tissues, such as in the liver or spinal cord.
“Organoids offer an unprecedented level of access into the inner workings of the human brain,” Novitch says, noting that our brains are largely off-limits to poking and cutting into for research. If scientists can study accurate models of working neural circuits in these brain bits, he and others say, researchers might finally get a handle on uniquely human neurological conditions. Such disorders, which include epilepsy and, experts theorize, schizophrenia and autism (SN Online: 7/17/15), can arise when the brain’s communication networks develop off-kilter.
But the research is still in its early days. Although there’s been exciting headway, studies sometimes overstate the extent to which human brain organoids reproduce features of actual developing brain tissue, says stem cell biologist Arnold Kriegstein of the University of California, San Francisco. The minimodels still lack many basic components, including certain cell types, a blood-vessel network and inputs from other neural regions.
Another stumbling block is that brain organoids can vary a lot from protocol to protocol, or even batch to batch within the same lab. “The major focus now needs to be on reproducibility, and being able to get an approach that you can rely on to give you the same outcome each time,” Kriegstein says.
DIY organs
For decades, biology research has relied on cell lines grown in flat sheets in petri dishes, but those sheets lack the structural complexity of living tissue. Then came pioneering work that unveiled the do-it-yourself magic of stem cells raised free-floating in broth.
Organlike tissue bits can be generated from pluripotent stem cells that are either plucked from embryos or created by taking a person’s adult skin or blood cells and chemically inducing them to revert to an embryonic-like state. Starting in the mid-2000s, Yoshiki Sasai’s team at the RIKEN Center for Developmental Biology in Kobe, Japan, demonstrated how to grow brainlike structures using embryonic stem cells, first from mice and then humans.

In their groundbreaking study in 2013 in Proceedings of the National Academy of Sciences, the researchers used chemical cues to direct human embryonic stem cells to form a specific region of the human cortex. (Tragically, Sasai committed suicide the next year, after two stem cell studies that he coauthored were retracted amid scientific misconduct charges against a research colleague [SN: 12/27/14, p. 25]. Before his death, Sasai was cleared of any direct involvement. The discredited studies were not related to the organoid research.)
A few months before the 2013 Sasai team paper, Madeline Lancaster and Juergen Knoblich of the Institute of Molecular Biotechnology in Vienna and U.K. colleagues demonstrated their more freewheeling, landmark approach to growing brain organoids (SN: 9/21/13, p. 5). The recipe, described in Nature, allows human pluripotent stem cells to spontaneously attempt to assemble into a tiny approximation of a whole brain by making whatever brain structures the stem cells choose.
Meanwhile, biologists elsewhere were whipping up other types of organoids, starting instead with adult stem cells. These rare, damage-repairing cells are found in many organs (including the brain), but the cells can transform into only a limited range of cell types. In 2009, Hans Clevers of the Hubrecht Institute in Utrecht, the Netherlands, announced that his lab unexpectedly created a miniature version of a gut while cultivating adult stem cells that the team had discovered in mouse intestinal tissue. Grown in a drop of Matrigel with a trio of growth-inducing factors, these cells coalesced into little spheres containing tiny projections that resembled the fingerlike villi that absorb nutrients in the gut.
Scientists soon were concocting tiny facsimiles of human stomachs, livers, kidneys, lungs and more (SN: 12/28/13, p. 20). “We essentially are discovering the vitality of what the stem cells actually do,” says Clevers, who is president of the International Society for Stem Cell Research. “We give [the cells] a little push, and they do whatever they’re good at.”
The trick is knowing exactly which ingredients to use to make different organs. For pluripotent stem cells, that means exposing them to just the right growth factors or inhibitors at just the right times, over about a month, says James Wells of the Center for Stem Cell and Organoid Medicine at Cincinnati Children’s Hospital Medical Center. Some of those essential instructions are well-known from decades of research on embryo development in fish, chickens and rodents; the same chemical cues generally work for all animals with spinal cords, including people.

However, for many body parts, organoid makers must suss out recipe instructions from scratch. Working with Jorge Múnera and other colleagues, Wells recently produced a minimodel of a human colon using human induced pluripotent stem cells. But first, the team conducted months of experiments on frog and mouse embryos to identify the signals for forming a colon. “It took a while to figure out what the special sauce was,” Wells says.
Some scientists have distant dreams of using organoid methods to grow full-size livers or kidneys in the lab for transplantation. A more attainable goal may be regenerative tissue transplants, for example, replacing dying liver cells in someone with early-stage liver disease with chunks of healthy stem cells from a personalized liver organoid. Or, in patients who’ve had part of the small intestine removed, tiny pieces of gut organoid tissue could be implanted and, after growing larger, connected to the intestine.
Head games
The human brain, meanwhile, is vastly more complicated than any other organ. It’s unlikely that scientists will ever be able to build a full replica. While the initial brain-making recipes were stunning for what they could achieve, they left much room for improvement. In the years since the 2013 debut of human brain organoids, research groups have worked to grow bigger brain tissue clumps and more uniform structures.
The Austrian method for making whole-brain organoids, in particular, produced a random mix of neural regions laid out in a topsy-turvy manner. But bioengineering tricks may help. In a study last year, Lancaster, now at the MRC Laboratory of Molecular Biology in Cambridge, England, and Knoblich got more consistent results by adding polymer filaments as scaffolding to guide the organization of the minibrain models.
Other scientists, following the Japanese approach, which generally gives more predictable results, have concentrated on coaxing out specific cell types or structural features of the real brain. For instance, one constraint is that the organoids form slowly, more or less sticking to the same timeline of development as does a human brain during gestation. But without a blood supply, growth is limited; the brain bits reach only a few millimeters in size. That means organoid models are often short on cell types from later development stages, such as cells called astrocytes. These star-shaped cells are crucial for creating and curating the connections between neurons, and also may help with forming memories (SN Online: 11/15/17).
Astrocytes don’t fully mature in a baby’s brain until after birth. But Stanford University neuroscientist Sergiu Paşca has crafted a method for making and maintaining 4-millimeter-wide balls of human cortex–like tissue (he calls them spheroids) in 3-D culture for an extended time. Last August in Neuron, his team described organoids that survived for more than 20 months — long enough, analyses showed, for astrocytes to mature and function in ways that mimic their real-brain counterparts.
Of great interest, also, are the outer radial glial (oRG) cells, neural stem cells that are pivotal for constructing the unusually big cortex that’s unique to humans; oRG cells are scarce in mouse brains. When Novitch’s lab group at UCLA tried the original Japanese and Austrian organoid-making recipes, the output of oRG cells was underwhelming. So Novitch worked with Vishlaghi and postdoctoral researcher Momoko Watanabe to refine the protocol to pump up the cells’ production and reliably generate better cerebral blobs.
Among other tweaks, Novitch’s team added a dash of a molecule dubbed LIF, which recent studies by others had suggested can spur the oRGs to multiply. It worked, leading to a threefold increase in the oRG populations and enhanced growth of upper neuron layers. The researchers shared their revised protocol last October in Cell Reports.
On a different front, labs have begun assembling more complex minibrain models, like playing with self-directed Legos. For two months, Paşca’s team at Stanford grew spheroids in separate sets of dishes that mimicked either cortex tissue or an adjacent underlying region known as the subpallium. Then the researchers put the different bits side-by-side and left them overnight in a culture tube. Similar to how the two regions normally connect in the developing brain, the little pieces knew what to do. “By the next day they are essentially fused to each other,” says Paşca, who announced the results in May in Nature.
During the fusion process, the researchers took time-lapse videos of long, spaghetti-like cells called interneurons migrating from a spheroid of the subpallium into a cortexlike spheroid.
“They don’t crawl, they actually jump,” Paşca says. The images capture aspects of a hallmark phenomenon that normally unfolds during the second and third trimester of fetal gestation.
Testing ground
Once on the other side, interneurons form a circuit with — and quell the activity of — excitatory neurons in the cortexlike tissue, electrophysiological tests suggest. If not quieted, excitatory neurons will trigger neighboring cells to fire. In the real brain, maintaining a proper balance in neural network activity is important; disruptions in it appear to foster disorders such as epilepsy, and perhaps schizophrenia and autism.
Indeed, in the same paper, the Stanford team reported new discoveries using personalized brain spheroids derived from induced pluripotent stem cells of patients with Timothy syndrome — a rare condition caused by an overactive calcium channel found mainly in the brain and heart. Patients with the disorder have epilepsy, autism and heart problems. In the patients’ spheroids, interneurons migrated inefficiently but, by adding drugs that blocked the dysfunctional calcium channel, the researchers could reverse the problem. The brain organoids made these intriguing observations possible, Paşca says. “We couldn’t have done this in any other way.”
Organoid experiments by others have, meanwhile, helped confirm that the Zika virus targets and kills oRG cells and other neural precursor cells, contributing to small brain size in infected infants.
In a 2016 study, Johns Hopkins University neuroscientists Guo-li Ming and Hongjun Song reported on their own techniques for creating brain bits that have a well-defined zone of oRG cells. After infecting these organoids with the Zika virus, the researchers observed a collapse of cortexlike tissue that may partly explain the stunted brain growth (SN: 4/2/16, p. 26). 2-D cell-culture and mouse experiments also provided key evidence of the virus’s modus operandi; although the rodent brain doesn’t harbor the full contingent of human neural stem cells, it has blood vessels and immune-system components that organoids lack.
In search of Zika-fighting treatments, Ming and Song, both now at University of Pennsylvania, and their colleagues have been screening thousands of compounds in 2-D cell cultures, and then validating the most promising candidates with tests in 3-D brain organoids. The team has found several potential antiviral and neuron-protecting agents to pursue. Novitch’s UCLA lab group has likewise used its brain organoids to pinpoint additional receptors by which the virus may gain entry into neural stem cells, and identified a few other drug leads for blocking infection.
Organoids may also prove valuable for tailoring treatments for patients, says David Panchision, chief of the developmental neurobiology program at the National Institute of Mental Health in Bethesda, Md. Researchers might generate personalized brain organoids from the reprogrammed skin cells of individuals with, say, schizophrenia and test which medications work best for patients with particular genetic profiles of the illness.
In the Netherlands, based on research reported in 2016 in Science Translational Medicine, Clevers and colleagues are already using personalized gut organoids, derived from rectal biopsies, to test whether cystic fibrosis patients will benefit from available drugs. Tailored regenerative therapies with 3-D substructures of neural tissue may also be possible, Panchision adds, for conditions like Parkinson’s disease or spinal cord injury.
Growing pains
For now, though, scientists have hefty challenges to overcome. Much work remains in optimizing how faithfully the bits of tissue reproduce normal brain function and architecture, Panchision says. For one thing, the organoids are developmentally young and don’t reflect a mature brain. And researchers must figure out how to build in some core features: the necessary blood vessels, immune-system cells called microglia and connections from other brain regions, such as the thalamus and cerebellum. Not to mention steroid and thyroid hormones, which also shape brain growth.
However, scientists don’t necessarily need or want to create a comprehensive replica of the human brain in a dish, Panchision and others point out. Rather, the goal is to build robust and reliable models for studying specific aspects of brain function.
Thus the pressing need for standardized, reproducible organoid-making recipes. Novitch’s group and many other labs are still trying to figure out why the brain bits can vary so much in size, composition and structure. Part of the trouble is the ingredients: Subtle variations in tissue-culture chemicals and Matrigel, or in different stem cell lines and how they are grown first in 2-D culture, can have a big impact on how the organoids turn out, Novitch says.
At the same time, researchers need to do a more thorough job of analyzing brain organoids to know what’s actually in them at different developmental time points, compared with actual human fetal brain tissue, says UCSF’s Kriegstein. It’s otherwise hard to say whether a brain blob truly recapitulates the neural tissue that scientists claim it does. Labs have started tackling the problem with a tool called single-cell transcriptome analysis, which gives readouts of all the genes that are active in individual cells.
“Greater rigor is needed,” Kriegstein says. “And I am sure we will eventually get there.”
This story appears in the March 3, 2018 issue of Science News with the headline, “Brain-making 101: Self-assembling clumps bring a dose of 3-D reality to studies of human organs.”




